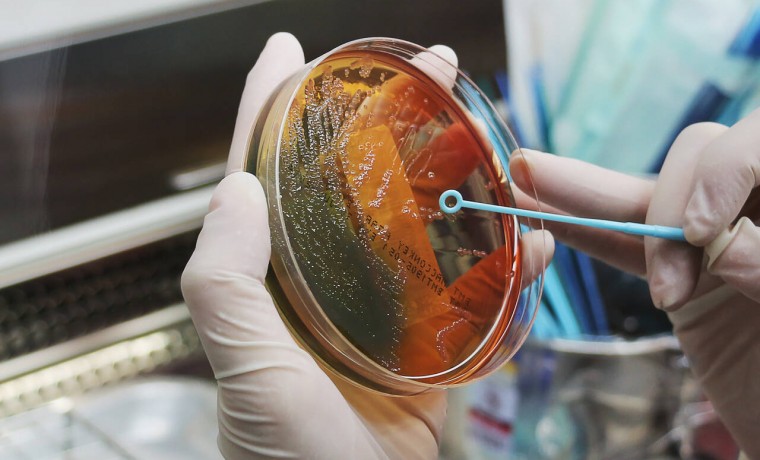

В России выявили вид бактерий активных против коронавируса
Нижегородский институт эпидемиологии и микробиологии имени И.Н. Блохиной совместно с Государственным научным центром вирусологии и биотехнологии «Вектор» выявил вид бактерий, который активен против COVID-19. Об этом сообщается на сайте Роспотребнадзора.
По результатам проведенных исследований было изучено взаимодействие шести штаммов лакто- и бифидобактерий с эпидемическим вирусом гриппа, высокопатогенным штаммом вируса гриппа птиц, а также новым коронавирусом.
«Установлено, что пробиотические штаммы лактобацилл и один штамм бифидобактерий проявляют выраженную активность против вирусов гриппа, а один из штаммов лактобацилл активен и в отношении вируса SARS-CoV-2», — установили ученые.
Результаты проведенной научной работы также опубликованы в зарубежном научном журнале Biomed Research International.
Ранее стало известно, что в России появится биочип для диагностики COVID-19. О новой разработке сообщил Роспотребнадзор.











